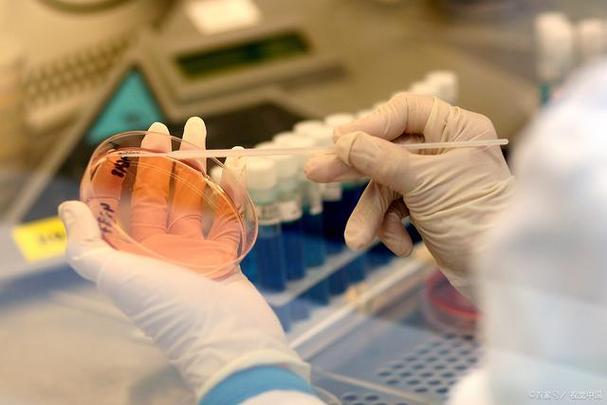

本文讲述了国内试管婴儿技术从艰难起步到蓬勃发展的历程,介绍了不同阶段的发展情况、成功率变化等,还提及面临的挑战与未来展望,展现了其为众多家庭带来生育希望的美好旅程 。
国内试管婴儿的成长之路:从实验室到家庭的美好旅程
在咱们中国人的传统观念里,拥有自己的孩子,那可是家庭圆满的重要标志。然而,现实生活中,却有不少夫妻因为各种原因面临着生育难题。好在医学技术不断进步,试管婴儿技术给这些家庭带来了新的希望。今天啊,咱们就来唠唠国内试管婴儿从实验室走向家庭的这段美好旅程。试管婴儿技术可不是一下子就成熟完善的,它在国内经历了漫长的发展过程。早在上世纪,国内的科研人员和医学工作者就开始关注这项技术,并着手进行研究和探索。当时,相关的技术和经验都十分匮乏,一切都得摸着石头过河。

艰难的起步阶段
在最初的时候,国内对于试管婴儿技术的研究条件十分艰苦。科研人员们在简陋的实验室里,凭借着对科学的执着和对帮助患者的信念,一步一步地摸索前行。1988 年,中国大陆首例试管婴儿在北医三院诞生,这一历史性的时刻,标志着国内试管婴儿技术迈出了重要的第一步。据统计,在早期,国内每年通过试管婴儿技术成功孕育的案例屈指可数。就拿 1990 年来说,全国范围内通过试管婴儿技术成功怀孕并分娩的案例仅有几十例。这个数据虽然不多,但每一个案例背后,都是一个家庭的希望。
| 年份 | 国内试管婴儿成功案例数 |
|---|---|
| 1990 年 | 约 50 例 |
那时候,社会上对试管婴儿技术还存在很多误解和偏见。不少人认为这是违背自然规律的,甚至还有一些不实的传闻。但是,随着越来越多健康可爱的试管婴儿诞生,人们逐渐开始了解和接受这项技术。
技术发展与完善阶段
随着时间的推移,国内对试管婴儿技术的投入不断加大,越来越多的科研人员和医疗机构参与到这项研究中来。技术也在不断地发展和完善。一方面,实验室设备得到了极大的改善,从简单的基础仪器到先进的高科技设备,为试管婴儿的培育提供了更好的条件。另一方面,医生们的技术水平也在不断提高。他们通过参加国际交流、学术研讨等活动,学习到了国际上先进的经验和技术。在这个阶段,国内试管婴儿的成功率也有了显著的提升。根据相关数据显示,到 2005 年左右,国内一些大型的生殖中心,试管婴儿的成功率已经从早期的不到 20%提高到了 30% - 40%。
| 年份 | 国内部分大型生殖中心试管婴儿成功率 |
|---|---|
| 2000 年 | 约 20% - 25% |
| 2005 年 | 30% - 40% |
这个时期,国内也涌现出了一批优秀的生殖医学专家,他们凭借着精湛的医术和丰富的经验,帮助了无数家庭圆了生育梦。而且,相关的法律法规也开始逐步完善,对试管婴儿技术的规范和管理起到了重要的作用。
蓬勃发展的如今
如今啊,国内的试管婴儿技术已经进入了蓬勃发展的阶段。越来越多的医疗机构具备开展试管婴儿技术的资质,服务也更加规范化和人性化。从最初的少数几家医院,到现在全国各大城市都有专业的生殖中心,为患者提供了更多的选择。成功率也有了进一步的提高。现在,一些顶尖的生殖中心,试管婴儿的成功率已经能够达到 50% - 60%左右。而且,技术也更加多样化,除了传统的试管婴儿技术,还发展出了第三代试管婴儿技术等,能够更好地满足不同患者的需求。
| 年份 | 国内顶尖生殖中心试管婴儿成功率 |
|---|---|
| 2015 年 | 40% - 50% |
| 2020 年 | 50% - 60% |
在这个过程中,有太多感人的故事。我认识一对夫妻,结婚多年一直没有孩子,四处求医问药,花费了大量的时间和金钱,心理压力也非常大。后来,他们来到了一家专业的生殖中心,经过详细的检查和评估,医生为他们制定了个性化的试管婴儿方案。经过几个周期的努力,终于成功怀孕。当听到孩子第一声啼哭的时候,这对夫妻激动得热泪盈眶。这样的故事,每天都在国内的各个生殖中心上演着。
面临的挑战与未来展望
虽然国内试管婴儿技术取得了巨大的进步,但是也面临着一些挑战。比如,地区之间发展不平衡,一些偏远地区的医疗资源相对匮乏,患者可能无法享受到优质的服务。另外,随着技术的发展,也带来了一些伦理和法律方面的问题,需要我们不断地去探讨和完善相关的制度。不过,我们有理由相信,随着科技的不断进步,国内试管婴儿技术的未来一定会更加美好。未来,技术可能会更加精准、高效,成功率也会进一步提高。而且,随着医疗资源的不断优化和整合,更多的患者都能够享受到这项技术带来的福祉。说不定在不久的将来,试管婴儿技术会变得更加普及和完善,帮助更多的家庭实现拥有孩子的梦想。
国内试管婴儿从实验室走向家庭的这段旅程,充满了艰辛与希望。每一步的发展,都凝聚着科研人员、医学工作者的心血和努力。它不仅是一项医学技术的进步,更是无数家庭幸福的寄托。让我们期待它在未来能够创造更多的美好!
好梦试管婴儿助孕网网上所有内容均出于传递更多信息之目的,并不意味着赞同其观点或证实其描述。
任何关于疾病的建议都不能替代执业医师的面对面诊断,请谨慎参阅。本站不承担由此引起的法律责任。








































